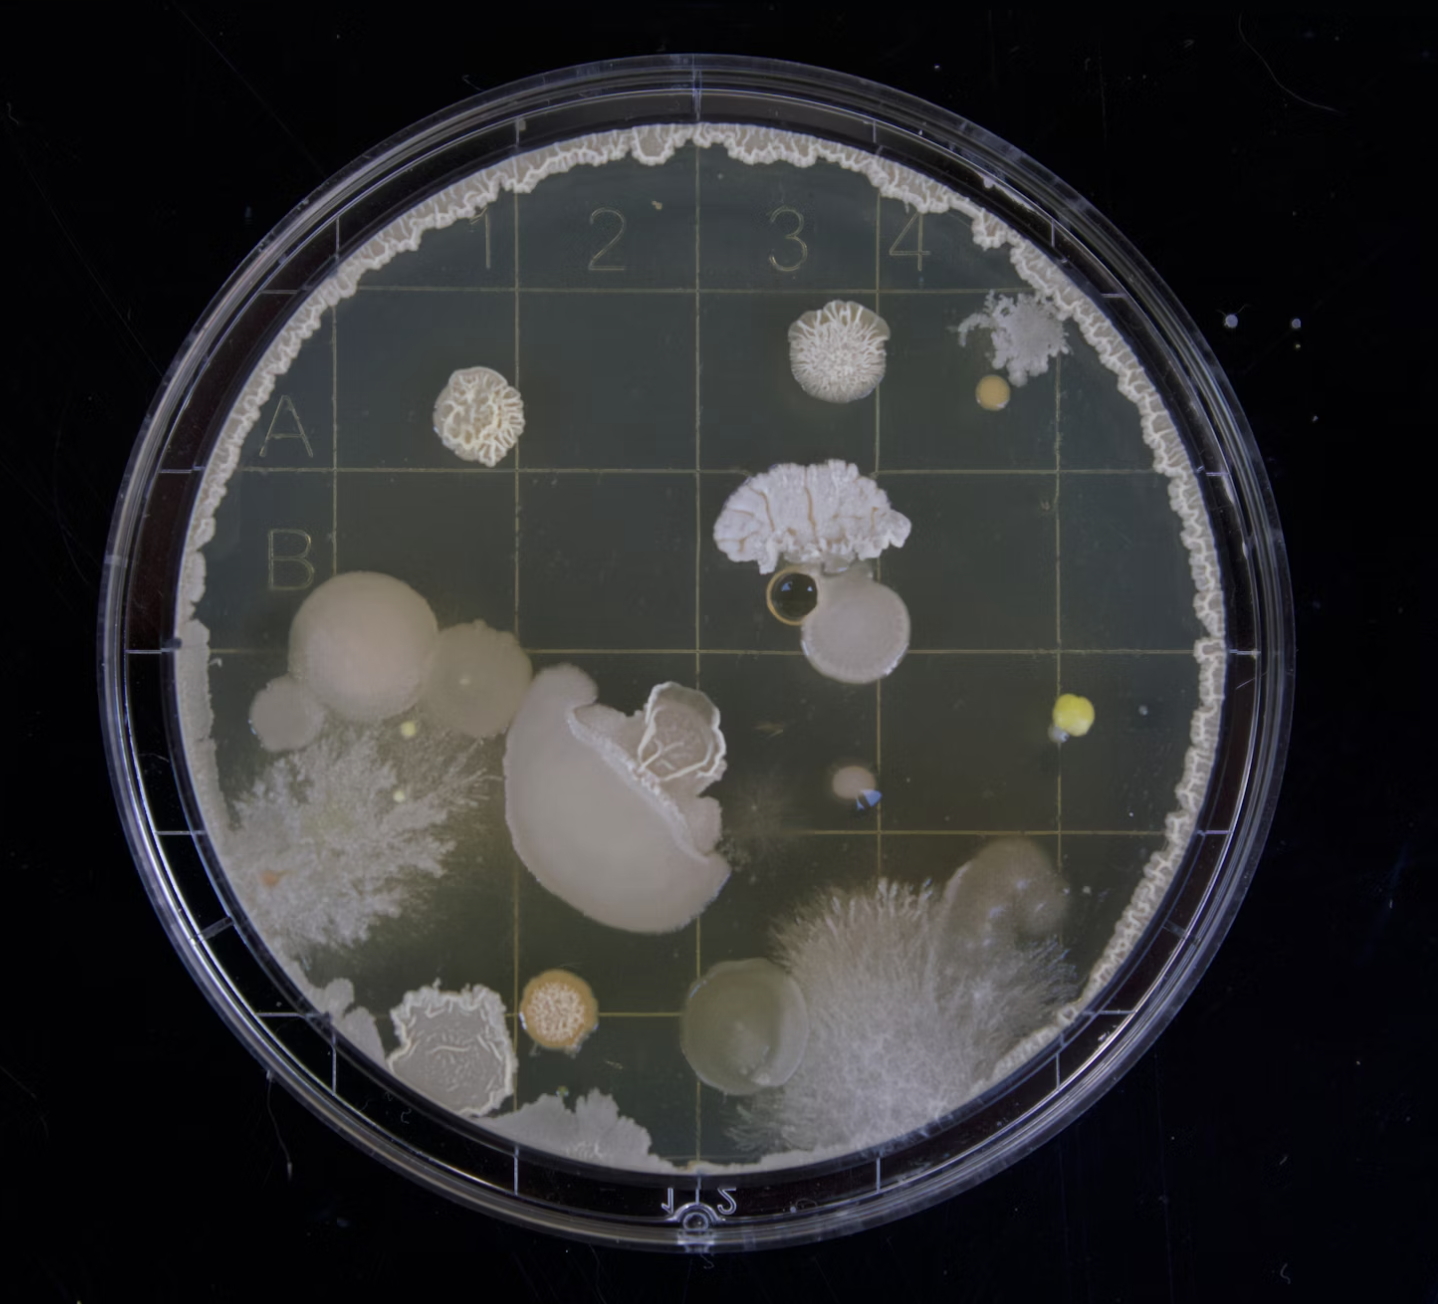
...

12PM
5PM in London (GMT), 2AM in Tokyo (GMT+9)
Welcome and Introduction by Exhibit Curators & Advisors
Moderators: Katy Börner, Indiana University
Panelists:
- Lisel Record and Todd N. Theriault, Indiana University
- André Skupin, San Diego State University
- Boris Eldagsen, Berlin-based Photographer and Video Artist
- Benjamin Wiederkehr, Founding Partner and Managing Director, Interactive Things
Click here to learn more about the third decade of the Places & Spaces exhibit.